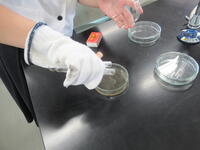

食品科学科
【本渡校舎】食品科学科1年生『トウモロコシの播種と看板設置』
晴天に恵まれ、トウモロコシの播種を行いました。
1時間の授業で慌ただしく実習を行いましたが、看板設置もでき、野菜栽培がスタートしました!!
次週は夏野菜の定植を行う予定です。
【本渡校舎】食品科学科1年生『実習室の清掃』
1年生のはじめての実習は掃除の仕方を学びました。
掃除用具にも様々なものがあり、用途に応じて使い分けることを学びました。
【本渡校舎】食品科学科3年生『晩柑マーマレード製造』
昨年度末に、本校本泉果樹園で収穫した、晩柑をマーマレードにしました。
3人一組で実習を行い、一人1瓶作り上げました。
ジャムを固めるペクチンは晩柑から抽出を行い、天然ペクチンでの製造ができました!!
【本渡校舎】食品科学科1年生『実習開始』
体育大会も終わり、通常日課の日々がスタートしました。
1年生食品科学科では初めて実習服にそでを通し、初めて実習室に入室をしました。
場所の確認や授業の流れなど確認事項がたくさんあり、生徒の皆さんは驚いていました。
まずは1年間頑張っていきましょう!!
【本渡校舎】食品科学科3年生『課題研究始動』
課題研究の授業では各班ごとにテーマを設定し、計画作成に取り組んでいます。
晩柑やビワといった地域の特産品を使う班や廃棄野菜を使う班などテーマは様々。
各班協力し合って、1年間頑張っていこう!!
【本渡校舎】食品科学科2、3年生『イチゴの下処理実習』
天草市五和町の寺田農園様よりイチゴを60kg購入しました。
このイチゴは、イチゴジャムの原材料で、2学年合同でヘタや不可食部を取り除く、下処理を行いました。
処理を終えた果実は冷凍保存します。
4月から学年が一つ上がり、上級生としての自覚が芽生えてきていました!!
【本渡校舎】食品科学科2年生『ビジネス文書検定に向けて』
2年生の「農業と情報」の授業ではビジネス文書検定の資格取得に向けて授業に取り組んでいます。
先生より効率の良い変換について説明があり、早速実践していました!
【本渡校舎】食品科学科3年生『猪肉まん』
前回の実習で挽肉にしたイノシシ肉を使い、肉まん製造を行いました。
挽肉とたまねぎ、タケノコ、ネギを炒め、味付けを行い、饅頭生地で包み、蒸し上げました!!
【本渡校舎】食品科学科3年生『イノシシ肉の下処理』
今年度初の実習は3年生のイノシシ肉の下処理となりました。
ミートチョッパーにかけられるサイズにカットし、不要部を取り除きました。
次週はイノシシ肉のひき肉を使った肉まん製造を行います!!
【本渡校舎】食品科学科『本渡北小6年生とのパン作り体験学習』
今回で2回目のパン体験学習会を実施しました。
18名の参加をいただき、ハンバーガー製造体験を行いました。
一人2個の製造を行い、持帰ってもらいました!!
本渡北小6年生とのパン作り体験学習会




ご参加いただきありがとうございました。
【本渡校舎』食品科学科1、2年生「晩柑下処理実習」
終業式後に、時間外総合実習を行い、先日収穫した晩柑の下処理を1、2年生合同で実施しました。
長時間の実習でしたが、協力をして実習ができました。
次年度のマーマレード用の原料になります!!
【本渡校舎】食品科学科1年生「ポップコーン製造実習」
自分たちで栽培して、収穫していたポップコーンの製造を行いました。
カレー味、キャラメル味、塩味の思い思いの味付けを行い、美味しく頂きました。
【本渡校舎】食品科学科1年生「最後の外での実習」
農業と環境の授業は1年次のみの授業なので今回の実習が最後となりました。
1年間使った自分の圃場の天地返しを行い、収穫も行いました。
次週は自分たちで栽培したポップコーンを実際に製造します!!
【本渡校舎】食品科学科2年生『晩柑収穫』
2月26日(月)4限目から本校本泉果樹園にて晩柑の収穫を行いました。
今回収穫した晩柑は、来年度の晩柑マーマレードの原材料になります。
この時期に収穫したほうが水分量が多く、歩留まりがよくなるそうです。
果樹の先生方の職人のような専門的な話に生徒たちも興味津々でした!!
【本渡校舎】食品科学科2年生『中和滴定②』
2年生食品化学では、果実中に含まれる有機酸の定量を行いました。
今回はレモン、オレンジ、ミカン、中庭で栽培している橙の4種類を調べました。
果汁を絞り、希釈して試料溶液を作り、滴定を行いました。



次回の授業で、各班のデータを集約して酸度の計算を行います。
【本渡校舎】食品科学科2年生『アイスボックスクッキー製造』
寒さ厳しく、雪が降る中、今回の実習はアイスボックスクッキー製造です。
1日目に生地作りを行い、一晩冷蔵庫で寝かせました。
2日目にカットと焼成を行いました。
≪1日目≫




≪2日目≫


【本渡校舎】食品科学科2年生『中和滴定法を用いた力価計算』
前回作製した水酸化ナトリウム水溶液の力価計算を行いました。
中和滴定を行うのは、2回目です。「微紅色」を出すのに苦戦している生徒もいましたが、集中して実験に取り組んでいました。



【本渡校舎】食品科学科2年生『水酸化ナトリウム水溶液の調整』
2年生食品化学では、これから中和滴定を行っていきます。
今回は、中和滴定の実験で必要な水酸化ナトリウム水溶液の調整を行いました。
班で協力をして、答えを導き出していました。


【本渡校舎】食品科学科3年生『アップルパイ製造』
先週製造したパイ生地に、リンゴのフィーリングを挟んだアップルパイが出来上がりました。
3年間様々なものを製造してきた食品製造の実習も今回で終わりです。
これまで学んだ製造技術や準備、後片付けの方法、友人と協力することなど社会に出てから生かせることもたくさんあったのではないでしょうか。
来週は卒業考査です。しっかりコンディションを整え、高校生活をまとめましょう!!








【本渡校舎】食品科学科2年生『ガトーショコラ製造』
2年生最初の実習はガトーショコラ製造!
メレンゲを使ったお菓子作りを行ってきましたが、このお菓子もメレンゲを使います。
2人1組で実習を分担して作り上げました。








【本渡校舎】食品科学科1年生『クッキー製造』
今年最初の1年生の実習内容はクッキー製造です。
今回は、油脂の多い中華風クッキー、その名も「チャイニーズアーモンドクッキー!!」
製造の様子をご覧ください。






1年生食品科学科は来週より、現場実習を行います。
また、2月には天草支援学校高等部のみなさんと交流活動を行います。
生徒は様々な行事を経験して、自分自身の成長につなげています。
【本渡校舎】食品科学科3年生『ヒラタケ栽培②』
年末にヒラタケの種菌接種を行い、培養がうまくいっています。
栽培びんの底まで菌が生育したので、びんの口部の古い種菌の塊等をかきとりました。
その後、補水を行い、原基の形成をうながします。
【本渡校舎】食品科学科3年生『アップルパイ製造』
3年生最後の食品製造実習の内容はアップルパイの製造です。
今回は生地作りを行い、冷凍庫で寝かせるところまで行いました。
次週はフィリングを作って完成です!!




【本渡校舎】食品科学科「パン製造体験学習会開催」
天草市立本渡北小学校児童の体験学習会を行いました。
今回は食パンとロールパンの製造体験を行いました。
生地作りは食品科職員で準備を行い、分割~成形~焼成まで行い、うまく焼きあがりました!!


【本渡校舎】12月23日(土)食品科学科体験学習会について
予定通り開催いたしますので、参加される方はお気をつけてお越しくださいませ。
【本渡校舎】食品科学科1年生「野菜収穫」
2学期最後の授業は冬野菜の収穫です。
肉加工実習等で授業が少なく、久しぶりに外で実習を行いました。
冬野菜も大きくなり、「鍋やおでんに入れてたべたいな」と話し声が聞こえてきました。


【本渡校舎】食品科学科2年生「チョコパイ製造」
12月19日(火)20日(水)にチョコパイ製造を行いました。
チョコクリームからパイ生地まで2人1組で協力して実習に取り組むことができました。
≪チョコクリーム≫


≪パイ生地≫






【本渡校舎】食品科学科『課題研究発表会』
3年生が1年間取り組んできた、課題研究の発表会が開催されました。
今年度は、食品コンテスト班、自家製燻製器製造班、廃棄農産物加工班、自家製ピザ窯製造班、天草の課題解決班、食品残渣活用班に分かれ、自分たちで授業の計画、立案、実施、反省、改善等を行い、研究に取り組みました。
8分間の発表時間に1年間の思いが詰まっており、すべての班が素晴らしい発表となりました。
1,2年生は発表を静かに聞き、1年後2年後を見据えて自分はどんなことをやろうかと考えているようでした。


【本渡校舎】食品科学科2年生『デコレーションケーキ製造』
2年生がデコレーションケーキの生地作りを行いました。
ココア生地の生徒もうまくいき、デコレーションするのが楽しみです!!




【本渡校舎】食品科学科1年生「クリスマス飾りパン製造」
クリスマスも近づき、テレビや街で聞こえる音楽もクリスマスソングが多くなってきました。
そこで、1年生ではもみの木風の飾りパン製造を行いました。
いつもより工程が多く、出来上がりのイメージがなかなかできずに苦戦する生徒もいましたが、上手に焼き上げることができました。




【本渡校舎】食品科学科3年生『ヒラタケの培養』
微生物利用の授業では、前回の授業で分離させた乳酸菌の観察を行い、ヒラタケの種菌接種を行いました。
年明けには、収穫できるようになっている予定です。
1月まで実験を継続していきます!!


【本渡校舎】食品科学科3年生「フィナンシェ製造」
10月の実習で余った卵白を冷凍させ、フィナンシェ製造を行いました。
2人1組で10個のフィナンシェを作りました。




実習の手際も、片付けも、先生の指導を聞く様子も、社会人になる自覚が色々なところで見受けられます。
【本渡校舎】食品科学科3年生『マルキーズ製造』
今回の実習はフランス菓子のマルキーズ製造。
実習の様子をご覧ください!!




4人一組で役割を自分たちで決めて、実習に取り組んでいました。
【本渡校舎】食品科学科1年生「スポンジケーキ製造」
クリスマスイブまであと20日。
食品科学科恒例のクリスマスケーキ製造がはじまりました。
1年生は、2人1組で生地製造を行い、担任の先生も一緒に参加されました。




生地は冷凍し、次回デコレーションを行います!!
【本渡校舎】食品科学科3年生『乳酸菌の分離②』
前回に引き続き、乳酸菌の分離を行いました。


2コマ目の授業はキノコ栽培のため米ぬかともみがらを混ぜて、培地を作りました。
【本渡校舎】食品科学科1年生「パウンドケーキ製造」
本校の販売用パウンドケーキは膨張剤を使用せず、製造を行いますが今回はベーキングパウダーを使い、膨張剤の力を借りて、ケーキ製造を行いました。
今回は自分たちで計量、準備も行い、各班協力して行いました。




今回の製品には牛乳とラム酒を入れ、香り豊かなパウンドケーキが出来上がりました。
【本渡校舎】食品科学科3年生「乳酸菌の分離」
食品中に含まれる、乳酸菌の分離を行いました。
今回はヨーグルトとキムチの中から乳酸菌を取り出します。



一週間30℃で培養を行います。どうなっているでしょうか!?
【本渡校舎】食品科学科3年生「スイートカボチャ」製造
文化祭も終わり、久しぶりの持ち帰り実習!!
今回はカボチャを使ったお菓子作り。スイートカボチャを作りました。




カボチャを蒸して、バター、砂糖、生クリーム、卵黄を混ぜ成形しました。
生地が柔く、成形しにくかったですがおいしくできました!!
【本渡校舎】食品科学科「拓心祭に向けた製造実習記録」
先日の拓心祭にはたくさんの方々にご来場いただき、本学科の製品をご購入いただき誠にありがとうございました。
今回のブログでは、拓心祭に向けた実習の記録を紹介いたします。
【肉加工】




【製菓】


今後の実習予定は期末考査後にケーキー製造やソーセージ製造を予定しております。
【本渡校舎】食品科学科3年生 灰分の定量(直接灰化法)の実験について
3年生の食品化学の実験で、灰分の定量法について学習しました。
るつぼの恒量等を求めています。
煙が出なくなるまで、予備灰化を行います。
次の実験で精秤を行いたいと思います!
【本渡校舎】食品科学科3年生「カボチャ入りパウンドケーキ製造」
ハロウィンも近づき、今回はカボチャ入りのパウンドケーキを製造しました。
持帰実習として製造を行いましたが、後日販売用を製造し、14日タイヨー祭で販売を行います。
実習の様子をご覧ください。




【本渡校舎】ハローウィンデザインの型抜きクッキー【2年生】
本日の実習では、2年生の食品製造では、ハローウィンデザインの型抜きクッキーを製造しました。
まず、生地を上手に伸ばしていきます。
伸ばした生地を型抜きしていきます。
オバケなどさまざまなクッキーを製造することができました!
【本渡校舎】食品科学科1年生「スパイラルアンパン製造」
中間考査前最後の実習は、1年生のスパイラルアンパンでした。
以前製造したアンパンの発展実習で、整形に時間がかかりましたが、無事実習時間内に終えました。




1人4個製造し、だんだんうまくなりました。



【本渡校舎】食品科学科3年生「練乳製造」
3年生の食品製造で練乳製造を行いました。
牛乳に砂糖と生クリームを入れ、煮詰め続けました。
パンに塗っておいしくいただきました!!


【本渡校舎】食品科学科 1年生 秋作の種まき、定植について
農業と環境の授業で、秋作の種まき、定植を行いました。
ニンジンやレタス、ダイコンなどを種まき・定植しました!
種まき・定植後にかん水を行いました。収穫を楽しみに成長を見守りたいと思います。
【本渡校舎】食品科学科 2年生 「拓心バーガー」製造 ②
本日の実習では、前回の反省点を活かして、拓心バーガーの製造実習を行いました。
文化祭に向けて、頑張りたいと思います!
【本渡校舎】食品科学科1年生「メロンパン製造」
9月25日1年生の製造実習はメロンパン製造です。
前回の実習の合間に、クッキー生地を準備し、冷凍させていたので、解凍を行い、実習に臨みました。
クッキー生地の扱いが難しく、手粉を使いながら、なんとか作り上げました!!





【本渡校舎】食品科学科3年生『乳酸菌分離用培地作成』
食品中から乳酸菌を分離させるため、GYP培地の作成を行いました。
殺菌を行い、次回の授業で使用します。


【本渡校舎】食品科学科3年生『アイスクリーム製造』
秋分の日が近づき「暑さ寒さも彼岸まで」というが言葉らしい気候になってきましたが、
昼間は夏日が続き、まだまだアイスクリームが似合う日が多そうです。
2人1組協力し、完成させました!!




【本渡校舎】食品科学科1年生「秋作の準備完了!」
農業と環境の授業で秋作の準備が完了しました。
天地返しを行い、畝立て、整地を行いました。
さあ!来週は種まき定植だ!!

【本渡校舎】食品科学科2年生「拓心バーガー製造」
今年の文化祭では食品科学科2年生が拓心ハンバーガーを販売予定です。
担当の先生と生徒たちが意見を出し合っています。
どんな製品ができるかとても楽しみです!!






【本渡校舎】食品科学科3年生『ヨーグルトの製造と乳酸菌分離の準備』
先週培養した乳酸菌が発酵し、ヨーグルトができました。
次回は、食品中から乳酸菌を分離したいと思っています。


【本渡校舎】食品科学科3年生『ダブルシュークリーム製造』
先週は生クリームを入れた、シュークリーム製造を行いましたが、今週はカスタードクリームを製造し、生クリームと合わせたダブルシュークリームを作りました。
チョコを溶かし、エクレア風シュークリームもできました。




【本渡校舎】食品科学科2年生『いちごジャム入りパウンドケーキ製造』
今回の実習は、膨張剤を利用したパウンドケーキ製造を行いました。
ケーキの中には、いちごジャムを入れ、焼き上げました!!



【本渡校舎】食品科学科1年生「あんパン」製造実習
本日の食品製造の実習では、あんパン製造を行いました。しっかり、あんを包んでいきます。上手に出来ています!
ゴマをつけて、美味しく仕上げりました!
【本渡校舎】食品科学科2年生 晩柑を活用した焼き菓子開発プロジェクト
各班に分かれて、晩柑を活用した焼き菓子開発プロジェクトを行いました!
各班工夫を凝らした焼き菓子を製造しています。
今後もアンケート結果をもとに、改善を続けていきます!
【本渡校舎】食品科学科3年生『乳酸菌の学習』
今回は微生物利用の授業で乳酸菌の学習を行いました。
実際に市販のヨーグルトの乳酸菌を利用して、脱脂粉乳と牛乳の2パターンで実験を行いました。


最後には乳酸菌について座学も行いました!!
【本渡校舎】食品科学科3年生『シュークリーム製造』
9月7日(木)の3年生食品製造の実習はシュークリーム製造です。
シュークリームの生地作りは短時間で行わなければなりません。
担当の先生の師範を見て、工程の確認を行い、下準備を行います。


各班シミュレーションを行い、製造に入ります。


生地を焼き始めたら、生クリームの準備です。

完成しました!!今回は全班成功!!次回はカスタードクリームを作り、wシュー製造を行います。

【本渡校舎】食品科学科3年生『食のアイデアコンテスト 特別賞受賞』
第5回『食のアイデアコンテスト』 主催:人間総合科学大学
ここ・から健幸グルメ部門 テーマ:郷土食または郷土の特産品を使った食品・レシピ開発
上記のコンテストに食品科学科3年生課題研究コンテスト班3名が応募し、特別賞を受賞しました!!
作品はこちら☟
「夏にピッタリ晩柑パンケーキ」
天草の晩柑でソースを作り、パンケーキの上にかけました。
ケーキの生地の中にも晩柑が入っています。
2学期も新たなコンテストに挑戦中!頑張ります!!
【本渡校舎】食品科学科1年生『夏野菜の片付け』
入学後、植え付けを行い、栽培管理をしてきた、ナス、ピーマン、オクラの片付けを行いました。
中にはまだまだ元気な株もありましたが、今後の秋作の栽培を行うためにすべて撤去しました。


【本渡校舎】食品科学科1年生『夏野菜最後の収穫とポップコーンの収穫』
朝晩は少し涼しさを感じ、秋が近くまで来ていることを感じられるようになってきました。
2学期最初の実習は収穫です!!冬野菜を植え付ける関係で夏野菜の栽培はもうすぐ終わります。
ポップコーンも収穫を行い、陰干しを開始しました。
来週からは片付けや冬野菜の準備等忙しくなりそうです。


【本渡校舎】食品科学科3年生『プリン製造』
2学期初の実習は3年生でした。今回はプリンの製造を行いました。
カラメルソース作りを先に行い、最後にプリン生地を入れて蒸して完成です!!
皆、顔を上げて担当職員の話を聞いています。




【本渡校舎】食品科学科1年生「農場管理」
お盆前に台風が接近し、お盆休みを挟んだため、収穫物がたくさんありました!!
暑い中でしたが、皆さん頑張りました!!

【本渡校舎】食品科学科 体験学習会 開催!!
本日、食品科学科の体験学習会を開催しました。今回の体験学習会は、普段の授業に近い形で、体験していきます。
製造したものは、「パウンドケーキ」になります!
食品科学科の2・3年生に教えてもらいながら、一緒に製造していきます。
メレンゲもしっかり作ることができました!
パウンドケーキを焼いている間に、座学で原理も学びます。
美味しく焼くことが出来ました!
天候が悪い中のご参加、ありがとうございました!
【本渡校舎】食品科学科 体験学習会(8月10日)の開催について
8月10日(木)の食品科学科の体験学習会は、予定通り開催いたします。
しかしながら、台風6号が本県に接近しつつあります。そのため、安全なご参加ができにくい場合は、ご参加を見合わせ、その旨を本校まで、ご連絡をお願いします。
今後の天候や警報・注意報、気象関連情報にお気を付けください。
お問い合わせ先
熊本県立天草拓心高校本渡校舎
TEL:0969ー23ー2141
【本渡校舎】食品科学科1年生 夏休み当番実習【野菜の収穫】
夏休みの当番実習で、ナス・オクラ・ピーマンなどの収穫を行いました。
暑い中でしたが、一生懸命収穫することができました!
夏休み期間中も農業高校ならではの学びがありますね!
【本渡校舎】食品科学科1年生「手ごねパン製造」
夏休みに入りましたが、時間外総合実習で1年生が手ごねパンの製造を行いました。
日頃の実習ではミキサーで生地作りを行っていますが、今回は自分たちの手で行いました。
悪戦苦闘しましたが、なんとか作り上げることができました!!




成形は1学期の復習だったためとてもスムーズでした!!
追伸、8月10日(木)に体験学習を開催します!!
詳しくは1つ前の食品科学科ブログを確認下さい!!
体験学習ポスター click こちらからも申込みができます!
【本渡校舎】8/10(木)食品科学科体験学習会開催!!
食品科学科でパウンドケーキ製造の体験学習会を下記の通り開催します。
参加希望の方は添付ファイルより申し込みお願いします。
たくさんの方のご参加お待ちしています!!
日 時:8月10日(木)
8時30分受付
9時00分開講
参加費:200円
場 所:天草拓心高等学校 本渡校舎
食品科学科実習室
対象者:天草管内の中学3年生
※参加者多数の場合は午後になる可能性があります
【本渡校舎】食品科学科1年生「夏野菜収穫とトウモロコシ管理」
猛暑の中、夏野菜はぐんぐん成長中!!
トウモロコシもぐんぐん成長中!!
収穫と管理を行いました。
【本渡校舎】食品科学科2年生「ロールパン製造」
2年生1学期最後の実習はロールパンの分割~成形~焼成までの実習を行いました。
1人4個の製造を行い、上手に焼き上げることができました。
また、今秋の文化祭では2年生がパン販売を行う予定にしているので、どんなパンにするかも考えています。






【本渡校舎】食品科学科2年生「ピザ製造」
6月に行った2年生の実習でブログ掲載が遅くなりましたが、実習内容を紹介します。
食品製造の実習にて、ピザ製造を通して、パン生地の取り扱い方法について学びました。
手で押さえて生地を伸ばしていきます。
生地にのせる具材も準備しています。
具材を包み、焼成すると・・・


【本渡校舎】食品科学科3年生「手指の細菌検査②」
先週の微生物利用で使用した培地を培養し、観察を行いました。
左から 手洗いをしていない
② 手洗いのみ
③ 手洗い後アルコール消毒
④ 手洗い後アルコール消毒後顔や髪を触る
以上のように条件を変え、先週触れた培地を観察しました。
手洗い、消毒の大切さを実体験しました。
【本渡校舎】食品科学科3年生「ロールケーキ製造」
1学期最後の実習はロールケーキ製造を行いました。
体験入学では中学生にロールケーキのロールを予定しているので、予行練習もかねて行いました。
みんな上手に巻きました!!




中学3年生のみなさんお待ちしてまーす!!
【本渡校舎】食品科学科2年生「銀鏡反応」
2年生の食品化学は銀鏡反応を行いました。実験の様子をご覧下さい!!


【本渡校舎】食品科学科1年生「夏野菜の誘引」
野菜には梅雨も、暑さも関係なく、順調に成長しています!!
授業中に雨が降ってくることもありましたが、みんなで夏野菜の管理を行いました。

【本渡校舎】食品科学科1年生「編み込みパン製造」
パン製造3回目は、生地を三つ編み四つ編みを行う、編み込みパンの製造を行いました。
担当の先生の師範をみんな注目して見ています!!




【本渡校舎】食品科学科3年生「手指の細菌検査」
前回の実験で製造した培地に、汚れた手、洗った手、消毒をした手、消毒をして汚した手の4パターンで培地に触れ、一週間培養を行います。培地は次週どうなっているでしょう!?

【本渡校舎】食品科学科3年生「バター製造」
生クリームから手作りバターの製造を行いました。
作ったバターは食パンに塗っていただきました。



【本渡校舎】食品科学科1年生「夏野菜収穫」
田植え、期末考査を挟んだ日程のため、久々の栽培管理実習となりました。
ピーマン、ナス、オクラは大きく成長し、収穫を迎えました。
小雨の降る中、生徒の皆さんは汗をかきながら、一生懸命実習に取り組んでいました。


【本渡校舎】食品科学科2年生「ホットドッグロール製造」
期末考査が終わり、久々の実習となりました。
2年生ではパン製造を繰り返し行っております。文化祭でどんなパンを販売するか検討しながら、実習を行っています。
今回はホットドッグロール製造です。
生地はミキサーで捏ね、分割から自分たちで行いました。






最後にトッピングを行い、完成です!!

【本渡校舎】食品科学科1年生「ロールパン製造その②」
今回の1年生の実習も、ロールパン製造を行いました。
効率よく、丁寧に実習を行えました。パン生地の扱い方にも慣れてきました。






【本渡校舎】食品科学科3年生「スライド培養観察」
先週行ったカビの培養後の観察を行いました。顕微鏡の中はこのようになっています。

次回の実験の準備も行いました。


【本渡校舎】食品科学科3年生「酸乳パール入りレアチーズタルト製造」
前回の実習で製造したタルト生地に、酸乳パール入りチーズを入れました。




しっかり固まり、おいしいレアチーズタルトができました。
【本渡校舎】食品科学科 食パン製造実習【2年生】
2年生の食品製造の実習で、食パンを製造しました。
生地を分割しています。
その後、ベンチタイムを10分程、取ります。
次に生地を成形していきます。
次に発酵させていきます。
生地が10分まできたら、オーブンで焼成します。
焼き上がったら、完成です!
【本渡校舎】食品科学科2年生「フェーリング反応」
食品化学の授業でフェーリング反応を行いました。
食品の中に還元糖が存在した場合、硫酸銅溶液を加えて加熱をすると赤褐色の沈殿を生じる現象のことをフェーリング反応といいます。アルカリ性の条件下で特に促進されるため、水酸化ナトリウム、酒石酸ナトリウムカリウムなどと一緒に加えて加熱を行います。
実験の様子です。




次回は沈殿した溶液の観察を行います。
【本渡校舎】食品科学科3年生「タルト製造」
前回実習で製造した酸乳パールを使い、レアチーズタルトの製造を行います。
今回はタルト生地の製造を行いました。




次週はこの生地にレアチーズケーキを流し入れます。
【本渡校舎】食品科学科1年生「ロールパン製造」
食品製造実習2回目の製造品目はロールパンでした。
機械で生地をこね、実習では分割、丸め、成形を行いました。




最後に卵水を塗り、オーブンで焼成を行い、完成しました。


初めてパンの生地を触り、なかなかうまくいかず難しかったようでした。
普通教科の担任、副担任の先生方も実習に参加され、楽しい雰囲気で実習が行われました。
【本渡校舎】食品科学科3年生「スライド培養2」
前回の微生物利用の授業では、培養の準備を行いましたが、今回はパンについたカビの培養を行いました。




2~3日、25℃の環境においておきます。実習は顕微鏡を使い、観察します。
【本渡校舎】食品科学科3年生「酸乳パール製造②」
スターターを添加した牛乳を、24時間保温し、乳酸発酵を行いました。
カードの破砕を行い、砂糖添加後殺菌を行います。


酸、香料を添加し、瓶に充填し完成しました。


一人1本持帰り、自宅や寮で水や炭酸水で5倍程度に希釈してみんなで飲んでください!!
【本渡校舎】食品科学科3年生「酸乳パール製造」
夏が近づき、じめじめする日も多くなってきました。
そんなときには本校の酸乳パールはいかがですか?
1本350円で販売中です!!
今回の実習は自分たちで酸乳パールの製造を行います。
まずは牛乳を殺菌し、スターターとなるヨーグルトを添加し、ヨーグルトを作りました。


一晩保温を行い、次回の実習で充填まで行います。

【本渡校舎】食品科学科1年生「夏野菜の管理」
梅雨の中休みに夏野菜(ナス、ピーマン、オクラ)の下葉かき、支柱立て、誘引を行いました。


ポップコーンは間引き、レタスは収穫。2時間の実習でしたが、皆黙々と管理実習に取り組みました。

管理を行った6月5日(月)の天気は曇りで気温も高くなく、実習日和でした。
【本渡考査】食品科学科3年生「ブッセ製造」
ブッセとは、フランス語で「ひとくち」という意味の焼き菓子の一種です。
3年生で生地作りからクリーム充填、包装まで行いました。

外はさっくりしていて、とてもうまくできました。
【本渡校舎】食品科学科2年生「晩柑の一次加工」
先日下処理を行った晩柑の一次加工を行いました。
各班に分かれて、様々な製品を製造しました。
ピールやマーマレードなど自分たちでレシピを考えました。



1つの班は晩柑果汁入りバームクーヘンを製造しました。


【本渡校舎】食品科学科2年生「デンプンの糊化」
食品化学の授業でデンプンの糊化を学ぶため、片栗粉から、わらび餅を作りました。
身近なものから食品化学を感じ取ることができました。


【本渡校舎】食品科学科1年生「エヒテルハイデサントクッキー製造」初実習!!
中間考査も終わり、1年生の初めての実習を行いました。
今回の授業で製造したのは、本校の販売用のクッキーでもあるエヒテルハイデサントクッキーです。




二人一組で協力して実習を行い、片付けまで時間内に終えることができました。
これから3年間でたくさんの製造実習に取り組んでいきます!!
【本渡校舎】食品科学科2年生「糖を加熱するとどうなる?」
2年生の『食品化学』では、炭水化物の学習を行っています。
今回は上白糖を加熱するとどうなるのか実験を行いました。
鍋に上白糖を入れ、ガスバーナーで加熱し、各段階の温度になったら、鍋から砂糖溶液をスプーンですくい紙皿に数滴落としていきました。



160℃~200℃で加熱すると独特の香りと味をもつ褐色物質が生成されるこの反応をカラメル化といい、実際に感じることができました。飴を上手に作る生徒もいました!!
【本渡校舎】食品科学科3年生「スライド培養の準備」
微生物利用の授業でカビの観察を行うため、スライド培養の準備を行いました。
使用するガラス器具を新聞紙で包み、乾熱殺菌します。

カビを培養するため培地作りを行います。今回はジャガイモを使用した、PDA培地を作ります。




できあがった培地はオートクレーブで121℃で15分間殺菌を行いました。
次回の授業ではカビを接種し、顕微鏡で観察を行う予定です。
【本渡校舎】食品科学科2年生「再び晩柑処理!!」
2年食品科学科では、晩柑を使った焼き菓子作りに取り組んでいます。
製造に先駆け、下処理を班別に行いました、これからの実習に期待しています。


【本渡校舎】食品科学科1年生「色々な作物、播種」
先週に引き続き、夏野菜の定植や播種を行いました。
今回はポップコーン、シソ、枝豆の播種、レタス、サツマイモの植え付けを行いました。
一人8種類の作物を栽培していまーす!!



【本渡校舎】食品科学科3年生「マヨネーズ製造とメレンゲクッキー製造」
前回に引き続き、卵の加工品であるマヨネーズの製造を行いました。
マヨネーズ製造では卵黄しか使用しないため、卵白が余ります。
そのためメレンゲクッキーにして、卵白を利用しました。
マヨネーズ製造の様子


メレンゲクッキー製造の様子


















































































































































































































































